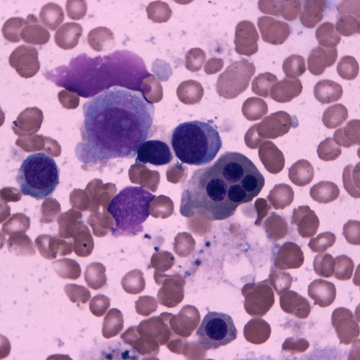
Čeští lékaři a vědci prodlouží život lidem s leukémií

Čeští lékaři a vědci prodlouží život lidem s leukémií
Tým vědců a lékařů z centra BIOCEV, 1. interní kliniky - kliniky hematologie 1. lékařské fakulty Univerzity Karlovy a Všeobecné fakultní nemocnice v Praze přišel s novým přístupem k léčbě akutní leukémie. Inovativní metoda spočívá v kombinaci dvou léčiv, které při společném podávání výrazně prodloužily přežití pacientů. Klinická studie probíhala pět let a zúčastnilo se jí 76 pacientů z České republiky. Informace o novém typu léčby publikoval prestižní časopis Blood Cancer Journal z Nature Publishing Group. Aktuálně probíhají jednání o rozšíření studie na evropskou úroveň.
Myelodysplastický syndrom (MDS) je onkologické onemocnění kostní dřeně, při kterém dochází k nízké produkci nefunkčních krevních buněk. Díky tomu mají pacienti nedostatek červených a bílých krvinek, klíčových pro obranyschopnost organismu, a dále i destiček pro krevní srážení. Pacienti trpící touto chudokrevností pak mají krevní podlitiny, častá vnitřní krvácení a jsou méně odolní proti bakteriálním a virovým infekcím, například zápalu plic.
Podle závažnosti onemocnění probíhá podpůrná léčba pomocí antibiotik či opakovanou krevní transfuzí. Ve výjimečných případech lze pacienty léčit transplantaci kostní dřeně. V Evropě jsou ročně diagnostikováni čtyři pacienti s MDS na 100 000 osob. V České republice registruje Všeobecná fakultní nemocnice přibližně 80 pacientů ročně. Kritickou fází onemocnění MDS je přechod do akutní myeloidní leukémie (AML), vyznačující se velmi krátkým přežitím.

„Dosavadní celosvětová léčba pacientů s MDS v přechodu do AML je postavena na podávání léku 5-azacytidin, který vynalezli v 70. letech minulého století v Československé akademii věd . Azacytidin je inhibitorem jaderných enzymů tzv. DNA metyláz, které jsou v leukemických buňkách geneticky i funkčně narušeny, a tudíž jejich ovlivnění vede k odstranění leukemických buněk. Naše MDS/AML skupina na základě předchozích výzkumů, z nichž řadu publikovaly renomované časopisy, přišla s konceptem tzv. ‚diferenciační terapie pro MDS‘. Navrhli jsme zkombinovat azacytidin s další látkou nazvanou G-CSF, podporující vznik a vývoj bílých krvinek v kostní dřeni. Nejen že se nám podařilo prokázat léčebné účinky nové kombinace a především její bezpečné působení na pacienty, ale také prodloužit jejich přežití v řádu měsíců,“ říká prof. Tomáš Stopka, vedoucí výzkumu z 1. lékařské fakulty UK a centra BIOCEV. „Zároveň jsme zjistili, že kombinace látek navodí signifikantně více léčebných odpovědí, což je přelomové a zásadní pro další výzkum i klinické testování na pacientech.“
Klinickou studii dokazující přínos nové léčebné metody u vysoce rizikového typu MDS schválil Státní ústav pro kontrolu léčiv v roce 2017. Koordinátorkou studie byla vedoucí pro léčbu a diagnostiku MDS a AML doc. Anna Jonášová z I. interní kliniky – kliniky hematologie 1. LF UK a VFN: „Obrovské úsilí jsme museli vynaložit už před začátkem samotné studie, kdy bylo třeba zajistit žádost na SÚKL a prosadit studii u etických komisí. Navržená léčebná kombinace posouvá využití cytokinu G-CSF do terapie AML a zároveň svým synergickým působením s azacytidinem činí tuto léčbu efektivnější a bezpečnější pro pacienty, a tudíž představuje ověřenou strategii, jež je okamžitě použitelná v praxi. Výsledků bychom nedosáhli, nebýt obrovské ochoty pacientů, kteří se do studie zapojili.“

V tuto chvíli probíhají intenzivní jednání o nové celoevropské studii, ve které bude předmětem výzkumu vedle 5-azacytidinu a G-CSF další lék venetoclax. „Jsem rád, že se nám v České republice daří úspěšně propojovat genetická a klinická data, a díky tomu určovat, jakým způsobem se bude akutní leukémie léčit v brzké budoucnosti,“ dodává prof. Tomáš Stopka.
Odkaz na publikaci: ZDE












